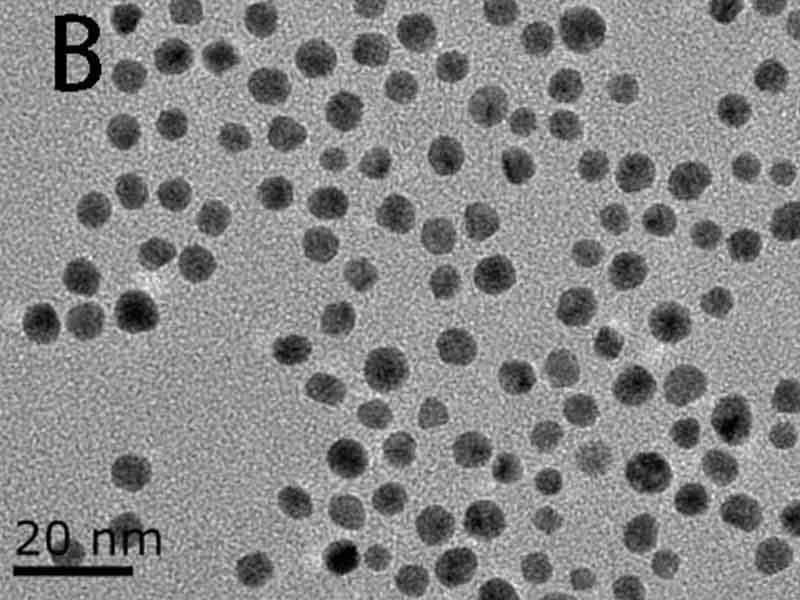
Test date shows higher crystallinity in melt blown nonwoven fibers by add our EP-6 water electret masterbatch.

EP-6, latest and best generation water electret masterbatch
With better and higher crystallinity, excellent dispersion performance, lower viscosity performance and stable and robust charge storage, our product will deliver unparalleled performance and reliability for your manufacturing needs.
EP-6 Water Electret Masterbatch now is the best in the market. Request free samples to test on your own production lines! You will love our products. For more EP-6 properties, please go to: Benefits of Water Electret Masterbatch.

Higher crystallinity, denser charge traps
Crystallinity refers to the degree of molecular ordering and arrangement in a material. By adding 3%-5% of our EP-6 water electret masterbatch into the polypropylene(PP) material, it possesses a greater level of molecular organization and structure. A higher degree of crystallinity can lead to improved material properties, such as increased strength, stiffness, and thermal stability.
After adding our water electret masterbatch, more charge traps are available within the melt-blown nonwoven fibers. Having denser charge traps can enhance the melt-blown fiber in capturing a greater number of charges and retain them within the material, resulting in, for the melt-blown nonwovens, better stability and performance.

Test data shows higher energy level, which means higer crystallinity in melt blown nonwoven fibers by add our EP-6 water electret masterbatch.
Excellent dispersion performance, higher specific surface area
Our EP-6 water electret masterbatch would really disperse uniformly and evenly within the matrix and the melt-blown material. Our masterbatch particles distribute themselves evenly throughout the material, this helps to avoid clumping or agglomeration and results in a more homogeneous and consistent production quality.
Effective dispersion increases the contact area between the water electret masterbatch and the surrounding fibers, resulting higher specific surface area, which can enhance the interaction. This can be beneficial for increased specific surface area, results in enhanced filtration and filtration efficiency.

SEM image on 100nm, this image shows that our masterbatch particles presenting elegant crystalline form.
SEM image on 20nm, in this image shows that our masterbatch particles disperse perfectly.
Lower viscosity, easier process adjustments and production
Our EP-6 water electret masterbatch would really disperse uniformly and evenly within the matrix and the melt-blown material. Our masterbatch particles distribute themselves evenly throughout the material, this helps to avoid clumping or agglomeration and results in a more homogeneous and consistent production quality.
Effective dispersion increases the contact area between the water electret masterbatch and the surrounding fibers, resulting higher specific surface area, which can enhance the interaction. This can be beneficial for increased specific surface area, results in enhanced filtration and filtration efficiency.
| NO. | Material | MFR (g/10min) | Viscosity (mPa·s) |
|---|---|---|---|
| 1 | EP-6 | 2356 | 5700 |
| 2 | EP-300 | 2135 | 8300 |
| 3 | T500 PP | 1750 | 12000 |
| 4 | Melt-Blown Grade PP | 1491 | 14000 |
| 5 | T700 PP | 105 | 180000 |
| 6 | PP | 6 | 3000000 |
Higher porosity and larger pore size leads to lower filtration resistance
The addition of our EP-6 Water Electret Masterbatch series, typically at a ratio of 3%-5%, during the PP production process and subsequent melt-blown fiber formation leads to melt-blown nonwovens with higher porosity and larger pore size, specifically referring to the structure and properties of the fibers within the nonwovens.
The increased porosity and larger pore size provide more pathways and spaces for air to flow through the nonwoven material, facilitating the filtration of particles and contaminants more effectively. This allows for smoother airflow, resulting in reduced pressure drop to just about 23 Pa and improved overall filtration performance to HEPA H13 (H13: 99.95% to 99.99%) level at over 99.98%.
| Term / Group | 1 (avg) | 2 (avg) | 3 (avg) |
|---|---|---|---|
| Resistance | 23.34 Pa | 22.46 Pa | 23.19 Pa |
| Filtration efficiency | 99.99399% | 99.98535% | 99.99422% |
Higher level of uniformity and finer fiber fineness
EP-6 enables the fibers to achieve a higher level of uniformity. When EP-6 Water Electret Masterbatch series are added to the nonwovens production process, they help in achieving a more consistent and even distribution of fibers within the nonwoven material. This can result in improved product quality and performance.
Fiber fineness refers to the thickness or diameter of the individual fibers. By using EP-6, nonwoven fibers become thinner, which can have benefits such as increased surface area and potentially improved filtration efficiency.

SEM image on 500μm, this image shows that by using our EP-6, results in more consistent and even distribution of fibers within nonwoven material.

SEM image on 50μm, this image shows that by using our EP-6, the average fiber diameter less than 2.2μm.
More surface micro-pore details, higher dust-holding capacity
When EP-6 is added to the nonwovens production process, it contributes to the formation of micro-pores on the surface of the nonwoven fibers. These micro-pores create a textured surface with intricate details, which can have various benefits such as increased surface area and enhanced adhesion properties, resulting in these EP-6 added nonwovens capturing and retaining a greater amount of dust particles.
EP-6 enhances the dust-holding capacity of the melt-blown nonwovens, and these nonwovens can be advantageous in applications where effective dust filtration or particle capture is desired.

SEM image on 5μm, this image shows that EP-6 Water Electret Masterbatch provides fine surface micro-pore texture details for melt-blown fibers.
Volatility under 0.15%MC, safer and more stable solution
The volatile content data of EP-6 fully complies with the national (China) requirement of ≤0.15%MC standard. It provides consistent and reliable performance throughout the production process. It is a great option that ensures safety and health for your melt-blown nonwoven products.

Volatility data of EP-6 Water Electret Masterbatch shows our product in full compliance with national standards. Compared to other products on the market, ours is even more better.
EP-6 technical data and packing info
1. Heat resistant temperature: 320℃
2. Physical dimension: (2.5±0.5)*3mm
3. Appearance: Milky white particles
4. Suggested ratio: 3%~5%
5. Pack information: 25 KG/Bag, 1 Ton/Pallet (and FYI, 1500 Tons/Year). Customized logo service available.
| Term / Data | Executive standard | Test Conditions | Typical value | Unit |
|---|---|---|---|---|
| Melt index | GB/T3682-2000 | 230℃, 2.16KG | 2350 | g/10min |
| Proportion | ISO-1183 | 23℃ | 0.9975 | g/cm³ |
| Melting point | DSC | 10℃/Min, N₂ | 168 | ℃ |
| Moisture content | GB/T6284 | 105℃, 2Hr | ≤1500 | PPM |
| Molecular weight | GPC | – | 45000 | MW |
| viscosity | B | 230℃ | 5700 | mPa·s |
| Softening point | ISO 4625 | Ring-and-ball | 130 | ℃ |
Customized EP-6 for discoloration or high-temperature
The issue of melt-blown nonwovens turning red or yellow can be resolved. We can offer tailored solutions specifically designed to address the problem of fiber discoloration.
We can provide customized EP-6 to maintain the performance and stability even under high-temperature conditions which can undergo a high-temperature test at 130℃ with a decay rate of ≤1%.

Melt-blown nonwoven fiber discoloration problem can resolved perfectly by customized EP-6 Water Electret Masterbatch.

Customized EP-6 added melt-blown nonwovens undergoing a high-temperature test at 130℃.